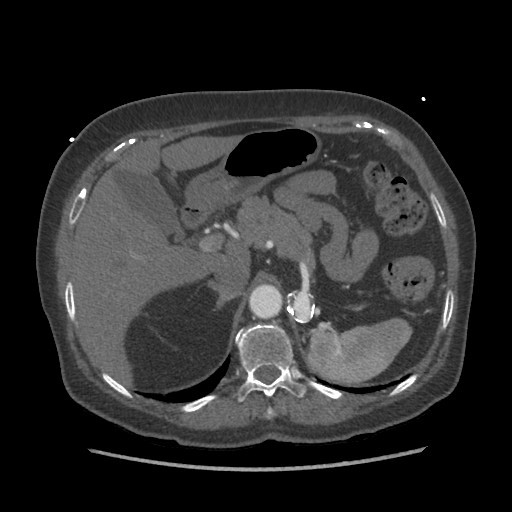

- Hammer to a peuter colour jaguar by a dominant person*
- with the number plate: PPPP*
Perioral Pigmentation, Polyps, Pancratic malignancy
ie hamatomas, peutz Jehger, autosomal dominant
Case courtesy of Dr Prashant Mudgal, Radiopaedia.org, rID: 38098
The pancreas appears bulky and shows an ill-defined isodense hypoenhancing mass measuring approximately 4.3 x 2.0 cm. There is extensive polypoidal thickening of upper gastrointestinal tract wall, involving the pylorus of stomach, duodenum, jejunum and proximal ileum. The polyps measure 5 to 30 mm and causing luminal compromise. The proximal small bowel appears distended till distal ileum and there is an ileo-ileal intussusception noted in the distal ileum. The terminal ileum and large bowel appear collapsed.
There are few enlarged non-necrotic lymph nodes noted in the mesentery, the largest lymph node measures 1.3 x 0.8 cm in size. There is a well defined oval mass measuring approximately 6.0 x 4.5 cm noted in the right adnexa. The right ovary could not be separately visualized from the mass. The mass shows post contrast enhancement and central non-enhancing necrotic region within.
Extensive polypoidal mucosal thickening predominantly affecting the upper gastrointestinal tract with pancreatic and ovarian neoplasms are likely to represent gastrointestinal polyposis syndrome most likely Peutz Jeghers Syndrome.
Case Discussion
Peutz-Jeghers syndrome (PJS) is an autosomal dominant inherited disorder characterized by intestinal hamartomatous polyps with a distinct pattern of melanin deposition in skin most commonly perioral regions.
Patients with PJS are 15-times more prone to develop GI malignancies. PJS patients are at high risk for developing pancreatico-biliary malignancies 1. There is also an association of ovarian neoplasm with PJS, most commonly granulosa cell tumor 2.
The patient had undergone GI endoscopy and biopsy and the diagnosis of PJS was confirmed on the histopathological appearance of a hamartomatous polyp.
What is the receptor of this tumour?

Case courtesy of Dr Hani Makky ALSALAM, Radiopaedia.org, rID: 8189
A soft tissue mass is noted in the fundus of the stomach, with lateral surface irregularity and gas locules on its surface. No exophytic/extra gastric component
No enlarged abdominal lymph nodes. No liver lesion within the limitation of the non contrast study.
Case Discussion
Upper GI endoscopy revealed a lesser curvature mass. Pathologically proven GIST.
GISTs have a KIT receptor Tyrosine kinase
DDX of BIG spleen and Little Spleen
- CTC p220
- BIG spleen
- Passive congestion
- heart failure
- portal HTN
- splenic vein thormbosis
- Lymphoma
- Leukaemia
- Gauchers
- Felty’s syndrome
- Neutropenia
- Rheumatoid arthritis
- Splenomegaly
- Passive congestion
- LITTLE SPLEEN
- Sickle cell
- post radiation
- post thorotrast
- malabsorption
- UC > CD
Thorotrast
Dr Rohit Sharma◉ and Radswiki◉ et al.
Thorotrast is a suspension of radioactive thorium dioxide first produced in Germany in 1928 and used as a contrast agent until the 1950s. Its principal use was for cerebral angiography: 90% of the estimated 50,000-100,000 patients treated received it for this purpose. Umbrathor was another thorium dioxide-based contrast medium which was principally used for assessment of the GI tract.
Basic principles
Thorotrast was an alpha emitter, which was retained by the body, a combination which make it highly carcinogenic. The deposition of Thorotrast was dependant on its radiological use, preparation method, and the age of the preparation. The primary site of deposition was the reticuloendothelial system including the liver, spleen, bone marrow, and lymph nodes.
Radiographic features
In patients treated with Thorotrast, a plain radiograph of the abdomen demonstrates fine, irregular metallic densities distributed throughout the liver, spleen, and peripancreatic lymph nodes 4.
Complications
Hepatic angiosarcoma is the classic Thorotrast-related neoplasm. Other associated cancers include:
cholangiocarcinoma
hepatocellular carcinoma
leukaemia
What sign is this and for which condition

Moulage sign and ceoliac disease
Loss of jejunal folds/mucosa
Citation, DOI and article data
The moulage sign is related to sprue, in particular coeliac disease. It occurs where there is a dilated jejunal loop with complete loss of jejunal folds 1. It is said to appear like a tube into which wax has been poured.
History and etymology
Moulage (French: casting/moulding) is the art of applying mock injuries to aid in the education of medical emergency teams. It was used as early as the renaissance when wax figures were used.

what is this sign and which condition is it associated with?

Hide-Bound sign of duodenum in scleroderma
Dr Evyn Arnfield and Dr Andrew Dixon◉ et al.
The hide-bound bowel sign refers to an appearance on a barium study of the small bowel in patients with scleroderma. The sign describes the narrow separation between the valvulae conniventes which are of normal thickness despite dilatation of the bowel lumen.
Although the term hide-bound is used specifically to describe scleroderma, the same appearance may also be seen in sprue. The stack of coins sign, although similar, should not be confused with the hide-bound sign. The former is seen in intramural hematoma as adjacent, thickened folds with sharp demarcation and crowding of the valvulae conniventes.
Pathology
The cause of hidebound appearance in scleroderma is thought to be asymmetric smooth muscle atrophy of the inner circular muscularis layer relative to the outer longitudinal layer. Contraction of the longitudinal layer results in foreshortening of the bowel and close packing of the valvulae conniventes.
History and etymology
The term hide-bound sign was coined by Alfred Horowitz and Morton Meyers in a study published in 1973, although according to their article the appearance had been described prior to that 3. The term hide-bound was originally used to describe emaciated cattle.
What is Whipples Disease?

Whipple disease (gastrointestinal manifestations)
Dr Hamish Smith◉ and Dr A Tachibana et al.
Gastrointestinal manifestations are a key component of Whipple disease. The gastrointestinal manifestations of Tropheryma whipplei are also known as intestinal lipodystrophy.
Pathology
Extensive infiltration of the lamina propria with large macrophages infected by intracellular T. whipplei causes marked swelling of intestinal villi and thickened irregular mucosal folds primarily in the duodenum and proximal jejunum. When they become large enough to be macroscopically visible, they may appear as innumerable small filling defects superimposed on irregularly thickened folds (sand-like nodules)
Radiographic features
Reported radiologic features include:
diffuse 1-2 mm micronodules (“sand-like nodules”) in the jejunum
thickened mucosal folds: especially the jejunum
small bowel caliber: normal or slightly dilated
mesenteric lymphadenopathy: nodes of very low (near fat) density 2

Which is more seen in UC than CD?
a. Creeping fat
b. Skip lesions
c. fissures
d. fistulae
e. Pseudopolyps

Case courtesy of Dr Maxime St-Amant, Radiopaedia.org, rID: 21015
e: pseudopolyps
Inflammatory pseudopolyp
Dr Ayla Al Kabbani◉ and Dr Maxime St-Amant◉ et al.
An inflammatory pseudopolyp is an island of normal colonic mucosa which only appears raised because it is surrounded by atrophic tissue (denuded ulcerative mucosa). It is seen in long-standing ulcerative colitis.
It must be distinguished from inflammatory polyps, which are regions of inflamed and elevated mucosa surrounded by granular mucosa.
Radiographic features
On CT scan or barium enema, inflammatory pseudopolyps appear as innumerable polypoid colonic filling defects. These area are usually enhancing on contrast-enhanced CT scan.

Felty syndrome
Assoc Prof Craig Hacking◉◈ and Dr Yuranga Weerakkody◉ et al.
Felty syndrome is a rare haematological syndrome in rheumatoid arthritis.
Epidemiology
It is thought to occur in ~ 1% of patients with rheumatoid arthritis 2.
Clinical presentation
Felty syndrome comprises of the triad of:
rheumatoid arthritis
typically with severe articular and extra-articular disease
splenomegaly
neutropenia
Additionally, patients may have bicytopaenia or pancytopaenia, recurrent bacterial infections, and non-cirrhotic portal hypertension.
Pathology
Serological markers
rheumatoid factor (RF): >95% of patients are positive 5
antinuclear antibody (ANA): 47-100% are positive 5
HLA-DR4*0401 antigen: 78% of patients have the antigen 5
large granular lymphocyte (LGL) expansion: ~ 30% of patients may have it 5
Treatment and prognosis
Treatment is through immunosuppression to treat Felty syndrome and rheumatoid arthritis, such as use of methotrexate and rituximab 6. If frequent severe bacterial infections, G-CSF may be administered 6.
History and etymology
It is named after Augustus Roi Felty (1895 -1964), an American physician 1.
Differential diagnosis
large granular lymphocyte (LGL) leukaemia 6
Which is more common, left or right sided CRC tumours?
Location:
“aging gut”
= number of right-sided lesions
increasing with age (“changing distribution”)
(a) left colon (52-61%):
rectum (15-33-41 %), sigmoid (20-37%), descending
colon (10-11%)
-commonly annular strictures with obstruction
(b) right colon:
transverse colon (12%), ascending colon (8-16%), cecum
(8-10%)
-commonly polypoid lesions with chronic bleeding
+intussusception
Colonoscopy: cecum not visualized in 10-36%;
fails to detect 12% of colonic polyps (10% in
areas never reached by colonoscope)
DAHNERT
Differences in clinical presentation and surgical management of right and left sided large bowel cancer are well known. For example, right sided tumours typically present at a more advanced stage with symptoms of weight loss and anaemia, whereas left sided tumours often present with rectal bleeding, change in bowel habit, and tenesmus.
https://www.ncbi.nlm.nih.gov/pmc/articles/PMC1122892/#:~:text=For%20example%2C%20right%20sided%20tumours,in%20bowel%20habit%2C%20and%20tenesmus.
? % of pts with this condition who develop CRC
- common cancers
- gene
- varieties (3)
Ddx

- Familial adenomatous polyposis syndrome
- ? % of pts with this condition who develop CRC
- 100%
- common cancers
- CRC
- Hepatoblastoma
- PeriAmpullary
- Papillary Thryoid
- gene
- APC gene on chromosome 5
- AD
- varieties (3)
- Familial polyposis Coli
- Gardener sydnrome
- Attenuated FAP
- Ddx
- juvenile polyposis syndrome
- Cowden syndrome (multiple hamartoma syndrome)
- Peutz-Jeghers syndrome
- Cronkhite-Canada syndrome
- ? % of pts with this condition who develop CRC
- Familial adenomatous polyposis syndrome (FAPS) is characterised by the presence of
- hundreds of adenomatous polyps in the colon.
- It is the most common of the polyposis syndromes.
- FAPS is used to described the entire spectrum:
- Familial polyposis coli,
- attenuated familial adenomatous polyposis and
- Gardner syndrome
- are all variants of the same disease
- Epidemiology
- 1 in 10,000 births
- average age of presentation is 16 years.
- Associations
- colorectal carcinoma (see below)
- hepatoblastoma (400-fold increased risk compared to general population)
- Periampullary carcinoma is the most common cause of death after prophylactic colectomy!
- extracolonic polyps (stomach, duodenum)
- desmoid tumours
- osteomas
- dental anomalies
- congenital hypertrophy of the retinal pigment epithelium
- papillary thyroid carcinoma - usually cribriform morular variant
- Clinical presentation
- Typical symptoms and signs include rectal bleeding, diarrhoea, abdominal pain, anaemia, and/or mucosal discharge 4.
- Polyps usually develop around puberty
- Pathology
- Familial adenomatous polyposis syndrome is characterised by the presence of hundreds or thousands of colonic adenomatous polyps, usually tubular or tubulovillous.
- The rectum is occasionally spared.
- Less commonly they affect the small bowel and stomach.
- Genetics
- AD
- Familial adenomatous polyposis syndrome results from mutation of the tumour suppressor adenomatous polyposis coli (APC) gene located on chromosome 5q21-2.
- Around one-third of cases are thought to be sporadic
- two-thirds thought to be familial
- MUTYH gene has been associated with APC-negative FAPS; this has an autosomal recessive inheritance 6 and this is often called MUTYH-associated polyposis (MAP).
- Variants
- There are three variants of FAPS:
- Gardner syndrome
- attenuated familial adenomatous polyposis
- familial polyposis coli
- There are three variants of FAPS:
- Radiographic features
- Familial adenomatous polyposis syndrome has a varied imaging appearance and demonstrate innumerable polyps.
- Imaging usually underestimates the number of polyps because most are <5 mm in size.
- Features of colorectal carcinoma (CRC) should also be actively sought out.
- Treatment and prognosis
- Familial adenomatous polyposis syndrome accounts for
- 0.5% of CRC cases with
- ~7% of FAP carriers developing CRC by age 21 with
- almost every carrier developing CRC by 35-40 years
- Total colectomy with ileoanal anastomosis is generally considered the surgical treatment of choice
- Familial adenomatous polyposis syndrome accounts for
- Differential diagnosis
- Cronkhite-Canada syndrome
- Peutz-Jeghers syndrome
- Cowden syndrome (multiple hamartoma syndrome)
- juvenile polyposis syndrome
? disease/syndrome
Cancers a/w. syndrome
Gene
incidence
age of presentation

Lynch Syndrome
= HEREDITARY NONPOLYPOSIS COLORECTAL CANCER
SYNDROME
= families with high incidence of colorectal cancers
+increased incidence of synchronous and metachronous
colorectal cancers
Amsterdam criteria :
(a) ;::3 family members of whom 2 are 1st degree relatives
of the third
(b) family members in ;::2 generations
(c) one family member diagnosed <50 years of age
Lynch I
no associated extracolonic cancer
Lynch II = associated with extracolonic malignancy:
transitional cell carcinoma of ureter+ renal
pelvis; adenocarcinoma of endometrium,
stomach, small bowel, pancreas, biliary tract,
brain; hematologic malignancy; carcinoma of
skin +larynx
Etiology: autosomal dominant abnormality of chromosome 2
with defect in DNA replication-repair process
(a) accelerated adenoma-carcinoma sequence
(b) dysplasia in flat mucosa of colon
Prevalence : 5-10% of patients with colon cancer;
5 x more common than familial adenomatous
polyposis syndrome
Mean age: 45 years
Location:
70% proximal to splenic flexure
Prognosis: better stage for stage than in other cancers
(5-year survival rate of 65% versus 44% in
sporadic cases)
Surveillance: colonoscopy every 1-2 years from ages
22-35 years
Hereditary non-polyposis colorectal cancer
Dr Owen Kang◉ and Assoc Prof Frank Gaillard◉◈ et al.
Hereditary non-polyposis colorectal cancer (HNPCC), also known as Lynch syndrome, is an autosomal dominant condition which predisposes to a host of malignancies, including colorectal carcinoma. It is considered the most frequent form of hereditary colorectal cancer. Diagnosis requires evaluation using clinical criteria (see: Amsterdam criteria for HNPCC).
Epidemiology
Lynch syndrome is the most common cancer syndrome, affecting 1 in 400 persons 3. Typically HNPCC patients present in their forties and fifties with colorectal cancer 2, or with one of the associated malignancies. It is 5 times more common than familial adenomatous polyposis syndromes (FAP) 6. It is the most common hereditary cause of endometrial cancer 9.
Pathology
HNPCC is due to mutations in DNA mismatch repair (MMR) genes 2, resulting most frequently in colorectal carcinoma (10-82% lifetime risk 9) as well as extracolonic malignancies, including 1,2:
genitourinary tract malignancies
endometrial carcinoma: 15-60% lifetime risk 9, most often endometrioid type
ovarian tumour: 4-12% lifetime risk 9
prostate cancer: 30% lifetime risk 9
urothelial tract cancer: 1-7% lifetime risk 9
small bowel cancer: ~5% lifetime risk 4
duodenum 45%
jejunum 29%
ileum 12%
not specified 14%
gastric cancer: 6-13% lifetime risk 9
hepatobiliary tract malignancies: 1-4% lifetime risk 9
pancreatic malignancies: 1-6% lifetime risk 9
CNS tumours: most often glioblastoma
There is a described association with breast malignancy, although the relationship is inconsistent 9. The MMR genes most commonly affected are MLH1, MSH2 (these two 70-85% of cases, MSH6, and PMS2 or EPCAM, an upstream gene in MSH2 expression 3.
Variants
Muir-Torre syndrome: HNPCC-variant with sebaceous tumours and keratoacanthocytomas
Radiographic features
Radiographic features are related to the underlying conditions:
colorectal carcinoma (CRC): more frequently right sided (70% proximal to the splenic flexure) 6. Despite the name, colorectal cancers arise from adenomatous polyps. Diffuse polyposis is characteristically absent.
small bowel adenocarcinoma: most commonly duodenal
endometrial carcinoma
ovarian tumours
urinary tract malignancies
Treatment and prognosis
The high risk of colorectal carcinoma warrants screening of the colon every 1 to 2 years starting from 25-40 years of age 2,3 and may require colectomy. With close surveillance and resection of any adenomas which develop, the risk of CRC can be reduced by 60% 3.
Due to a high number of extracolonic tumours, various screening programs have been instituted. Examples include transvaginal ultrasound screening of the uterus and ovaries (in post-menopausal women 9, at the clinician’s discretion) and serum CA-125 2. One follow up regimen recommends annual transvaginal ultrasound and endometrial biopsy 3, although screening should be individualised 9.
History and etymology
Lynch syndrome was first described by Aldred Scott Warthin (1866-1931) 8, an American pathologist, from University of Michigan in Ann Arbor, Michigan, in 1913, after research into a family with several members with cancers. In the mid 1960s, Henry T Lynch (1928-fl.2019), an American oncologist, published further detailed painstaking work on the same family studied by Warthin, shedding further light on these apparently hereditary cancers 7. The condition was later renamed after Lynch who doggedly pursued the then heterodoxy that cancer could be hereditary
In the left upper quadrant, anterior to the renal pelvis, is a focal region of mural thickening with consistent (in a patient with known Lynch syndrome) with a DJ flexure adenocarcinoma. Note the previous colectomy.
Case Discussion
This patient has known Lynch syndrome and has had prophylactic colectomy.
Presents with DJ flexure adenocarcinoma, confirmed at laparotomy.
What tumour of the stomach is most common.
? pattern of spread/N/M disease
5 year survivival for N2 disease
Most common cell type.
Most common location

GASTRIC CARCINOMA
0 3rd most common GI malignancy after colorectal +
pancreatic cancer, 6th leading cause of cancer deaths
Prevalence: declining; 24,000 cases/year in USA
Risk factors:
smoking, nitrites, nitrates, pickled vegetables
Predisposing factors:
H. pylori gastritis, chronic atrophic gastritis, adenomatous
+villous polyp (7-27% are malignant), gastrojejunostomy,
partial gastrectomy (Billroth II> Billroth I), pernicious
anemia (risk factor of 2), Menetrier disease (?)
Histo: adenocarcinoma (95%); rarely squamous cell
carcinoma I adenoacanthoma
Staging:
Tl
tumor limited to mucosa I submucosa
T2
tumor involves muscle I serosa
T3
tumor penetrates through serosa
T4a invasion of adjacent contiguous tissues
T4b invasion of adjacent organs, diaphragm, abdominal
wall
N1
involvement of perigastric nodes within 3 cm of
primary along greater I lesser curvature
N2
involvement of regional nodes >3 em from primary
along branches of celiac axis
N3
paraaortic, hepatoduodenal, retropancreatic,
mesenteric nodes
Ml
distant metastases
Location:
mostly distal third of stomach + cardia; 60% on
lesser curvature, 10% on greater curvature;
esophagogastric junction in 30%; transpyloric
spread in 5-25% (for lymphoma 40%)
Probability of malignancy of an ulcer:
at lesser curvature 10-15%, at greater curvature 70%, in
fundus 90%
Mnrphnlngy:
1. Polypoid I fungating carcinoma
2. Ulcerating I penetrating carcinoma (70%)
3. Infiltrating I scirrhous carcinoma (5-15%)
=linitis plastica
His to: frequently signet ring cell type +increase in
fibrous tissue
Location:
antrum, fundus+ body (38%)
>/ firmness, rigidity, reduced capacity of stomach,
aperistalsis in involved area
>/ granular I polypoid folds with encircling growth4. Superficial spreading carcinoma
= confined to mucosa I submucosa; 5-year survival of
90%
,J patch of nodularity
,J little loss of elasticity
5. Advanced bulky carcinoma
• GI bleeding, abdominal pain, weight loss
UGI:
,J rigidity
,J filling defect
,J amputation of folds ± ulceration ± stenosis
,J miliary I punctate calcifications (mucinous
adenocarcinoma)
CT:
,J irregular nodular luminal surface
,J asymmetric thickening of folds
,J mass of uniform density I varying attenuation
,J wall thickness >6 mm with gas distension + 13 mm with
positive contrast material distension:
,J diffuse low attenuation in mucinous carcinoma
,J increased density in perigastric fat
,J en han cement exclusively in linitis plastica type
,J nodules of serosal surface(= dilated surface lymphatics)
,J diameter of esophagus at gastroesophageal junction larger
than adjacent aorta (DDx: hiatal hernia)
,J lymphadenopathy below level of renal pedicle (3%)
Metastases:
1. along peritoneal ligaments
(a) gastrocolic Jig.: transverse colon, pancreas
(b) gastrohepatic + hepatoduodenallig.: liver
2. local lymph nodes
3. hematogenous: liver (most common), adrenals, ovaries,
bone (1.8%), lymphangitic carcinomatosis of lung (rare)
4. peritoneal seeding:
on rectal wall
= Blumer shelf
on ovaries
= Krukenberg tumor
5. left supraclavicular lymph node= Virchow node
Prognosis :
overall 5-year survival rate of 5-18%, mean survival time of
7-8 months;
85% 5-year survival in stage T1
52% 5-year survival in stage T2
47% 5-year survival in stage T3
17% 5-year survival in stage N1-2
5% 5-year survival in stage N3
Gastric adenocarcinoma
Dr Mohammad Taghi Niknejad and Dr Bruno Di Muzio◉◈ et al.
Gastric adenocarcinoma, commonly, although erroneously, referred to as gastric cancer, refers to a primary malignancy arising from the gastric epithelium. It is the most common gastric malignancy. It is the third most common GI malignancy following colon and pancreatic carcinoma.
Epidemiology
Gastric cancer is rare before the age of 40, but its incidence steadily climbs after that and peaks in the seventh decade of life (from 50 to 70 years) with males predominating at 2:1 2,10. The median age at diagnosis of gastric cancer in the United States is 70 years for males and 74 years for females.
Clinical presentation
It often produces no specific symptoms when it is superficial and potentially surgically curable, although up to 50% of patients may have nonspecific gastrointestinal complaints such as dyspepsia 2.
Patients may present with anorexia and weight loss (95%) as well as abdominal pain that is vague and insidious in nature. Nausea, vomiting, and early satiety may occur with bulky tumours that obstruct the gastrointestinal lumen or infiltrative lesions that impair stomach distension 2.
Several nodal metastases with eponymous names associated with gastric cancer have been described:
sister Mary Joseph’s node
Virchow’s node
Krukenberg’s node
Irish node
Pathology
Adenocarcinoma is by far the most common gastric malignancy, representing over 95% of malignant tumours of the stomach 1.
Aetiology
Gastric cancer continues to be one of the leading causes of cancer-related death. A significant development in the epidemiology of gastric carcinoma has been the recognition of the association with Helicobacter pylori infection. Most gastric cancers occur sporadically, whereas 8-10% have an inherited genetic component.
Risk factors
pernicious anaemia 7
adenomatous gastric polyps 7
atrophic gastritis 7
Billroth II partial gastrectomy for benign disease (e.g. peptic ulcer disease)
reflux of bile and pancreatic juice as thought to be carcinogenic 8
type A blood group 9
smoking 10
Radiographic features
Endoscopy is regarded as the most sensitive and specific diagnostic method in patients suspected of harbouring gastric cancer. Endoscopy allows direct visualisation of tumour location, the extent of mucosal involvement, and biopsy (or cytologic brushings) for tissue diagnosis 3. But radiological methods are often the initial examination that raises suspicion for gastric carcinoma, besides being used in the staging of the disease.
Fluoroscopy
Early gastric cancer (elevated, superficial, shallow):
type I: elevated lesion, protrudes >5 mm into the lumen (polypoid)
type II: superficial lesion (plaque-like, mucosal nodularity, ulceration)
type III: shallow, irregular ulcer crater with adjacent nodular mucosa and clubbing/fusion/amputation of radiation folds 4
Advanced gastric cancer:
polypoid cancer can be lobulated or fungating
lesion on a dependant or posterior wall; filling defect in barium pool
lesion on non-dependant or anterior wall; etched in white by a thin layer of barium trapped between edge of mass and adjacent mucosa
ulcerated carcinoma (penetrating cancer): 70% of all gastric cancers 4
Ultrasound
Not useful, unless a large epigastric mass is present or on endoscopic ultrasound study.
CT
CT is currently the staging modality of choice because it can help identify the primary tumour, assess for the local spread, and detect nodal involvement and distant metastases 1.
Demonstration of lesions facilitated by negative contrast agents (water or gas):
a polypoid mass with or without ulceration
focal wall thickening with mucosal irregularity or focal infiltration of the wall
ulceration: gas-filled ulcer crater within the mass
infiltrating carcinoma: wall thickening and loss of normal rugal fold pattern 4
Calcifications are rare but when present, they are usually mucinous adenocarcinoma.
Treatment and prognosis
It is an aggressive tumour with a 5-year survival rate of less than 20%. Prognosis is correlated to the stage of the tumour at presentation. Therefore, accurate staging of gastric cancer is essential because surgical resection is the treatment for localised disease 1.
Complications
perforation with peritonitis: rare (thought to occur in ~2% of cases) 5,6
Differential diagnosis
The imaging differential can be broad and includes:
gastric lymphoma
gastric metastasis
gastric stromal tumour (GIST)
carcinoid tumour
gastritis
benign gastric (peptic) ulcer
Menetrier disease
secondary changes from pancreatitis (from extrinsic inflammatory change)
CT of the abdomen demonstrates a mass arising from the greater curvature of the body of the stomach. It is centrally ulcerated with locules of gas and contrast seen within it, but without evidence of perforation. It is a focal abnormality with thick heaped-up shoulders.
At the splenic hilum there appears to be an enlarged lymph node (this should be confirmed on thin slice and coronal reformats). No convincing evidence of metastatic disease.
The left kidney is atrophic and contains a number of what appear to be hyperdense cysts (which should be confirmed on ultrasound). The right kidney has a large simple cyst.
2 case questions available
This patient went on to have a total gastrectomy after the stomach tumour was identified on gastroscopy.
Gastric adenoma is a premalignant lesion.1 Although the risk of progression from adenoma to gastric cancer is relatively low,2,3 adenomas can progress to invasive carcinoma4 or even advanced gastric cancer.3 Endoscopic forceps biopsy is the gold standard for histological diagnosis of adenoma before endoscopic resection (ER). However, the histological discrepancy rate between the results of biopsy specimens and those obtained at ER was noted to be considerably high in recent studies.5–8 Reportedly, 6.4% to 30.1% of biopsy-diagnosed low-grade adenomas are finally diagnosed as high-grade ones and 3.8% to 11.0% as adenocarcinomas after ER

top 2 most common sites of this disease Involvement

Sites of Involvement
The liver was the most frequent site of involvement in our study (74.8% of cases). Of the 275 patients with liver involvement, 133 (48.3%) had isolated liver involvement, 74 (26.9%) had concomitant liver and lung involvement, and 68 (24.7%) had concomitant involvement of the liver and of organs other than the lung (,Table).
The second most common site of involvement in our series was the lung (n = 89 [24%]). Seventy-four of these 89 cases (83.1%) demonstrated isolated lung involvement. Other sites of involvement (in decreasing order of frequency) included the peritoneum, kidney, brain, mediastinum, heart, bone, soft tissues, spinal cord, spleen, pleura, adrenal glands, bladder, ovary, scrotum, and thyroid gland (,Table). Ovarian and thyroid gland involvement in our study were not systemic, whereas bladder and scrotum involvement were concomitant with liver and peritoneal disease.
https://pubs.rsna.org/doi/full/10.1148/rg.232025704
Hydatid disease
Dr Mostafa El-Feky◉ and Assoc Prof Frank Gaillard◉◈ et al.
Hydatid cysts result from infection by the Echinococcus tapeworm species and can result in cyst formation anywhere in the body.
Epidemiology
Cystic echinococcosis has a worldwide geographical distribution. The Mediterranean basin is an important endemic area 6,7.
Pathology
There are two main species of the Echinococcus tapeworm 1,2:
Echinococcus granulosus
more common
pastoral: the dog is the main host; most common form
sylvatic: the wolf is the main host
Echinococcus alveolaris/multilocularis
less common but more invasive
fox is the main host
Definitive hosts are carnivores (e.g. dogs, foxes, cats), and the intermediate hosts are most commonly sheep. Humans are accidental hosts, and the infection occurs by ingesting food contaminated with Echinococcus eggs 3.
Cyst structure
The cysts usually have three components 1,2:
pericyst: composed of inflammatory tissue of host origin
exocyst
endocyst: scolices (the larval stage of the parasite) and the laminated membrane are produced here
Cyst classification
Based on morphology the cyst can be classified into four different types 2:
type I: simple cyst with no internal architecture
type II: cyst with daughter cyst(s) and matrix
type IIa: round daughter cysts at the periphery
type IIb: larger, irregularly shaped daughter cysts occupying almost the entire volume of the mother cyst
type IIc: oval masses with scattered calcifications and occasional daughter cysts
type III: calcified cyst (dead cyst)
type IV: complicated cyst, e.g. ruptured cyst
For hepatic hydatid infection on ultrasound also refer to World Health Organisation 2001 classification of hepatic hydatid cysts.
Location
hepatic hydatid infection: most common organ (76% of cases) 1,5
pulmonary hydatid infection: second most common organ (15% of cases)
splenic hydatid infection: third most common organ (5% of cases) 8
cerebral hydatid infection
spinal hydatid infection
retroperitoneal hydatid infection
renal hydatid infection
musculoskeletal hydatid infection
mediastinal hydatid infection (very rare) 9
Markers
Casoni skin test
Radiographic features
A chest film or other plain films can be the first diagnostic modality when echinococcosis is suspected, depending on clinical indications.
CT and MRI imaging are indicated when considering surgical treatment, particularly in regions like the brain, spine, and locations inaccessible for conventional radiography or ultrasound, or in case of diagnostic uncertainty.
Ultrasound
The Gharbi ultrasound classification consists of five stages 4:
stage 1: homogeneously hypoechogenic cystic thin-walled lesion
stage 2: septated cystic lesion
stage 3: cystic lesion with daughter lesions
stage 4: pseudo-tumour lesion
stage 5: calcified or partially calcified lesion (inactive cyst)
Treatment and prognosis
Four treatment options are currently available 7:
surgical excision
PAIR (Puncture, Aspiration, Injection of protoscolicidal agent and Reaspiration)
chemotherapy with an anti-helminthic agent (albendazole, mebendazole)
watch and wait for inactive and silent cysts
Treatment outcomes were improved when surgery or PAIR was combined with benzimidazole given before and after surgery 7. Regarding medical management, higher scolicidal and anti-cystic activity was seen in combination therapy with albendazole plus praziquantel and was more likely to result in cure or improvement 7.
5 causes of splenic infarct
Splenic infarction
Dr Mohamed Saber and Dr Yuranga Weerakkody◉ et al.
Splenic infarction is a result of ischaemia to the spleen, and in many cases requires no treatment. However, identification of the cause of infarction is essential.
Epidemiology
Splenic infarcts can occur due to a number of processes, involving either arterial supply, the spleen itself or the venous drainage. As such there is no one affected demographic; rather the demographics will vary with the underlying cause.
Clinical presentation
Patients with a splenic infarction may present with left upper quadrant pain. Some may have constitutional symptoms such as fevers and chills while others may even have diffuse abdominal pain 5,9. Due to the location of the spleen, tucked under the left hemidiaphragm, referred pain to the left shoulder is also a feature 9.
It should be noted that ~40% (range 30-50%) of patients with splenic infarction are asymptomatic 9.
Pathology
Aetiology
The majority of patients with splenic infarcts have one of the following two aetiologies:
haematologic disorders
more common in younger patients
e.g. sickle cell disease
hypercoagulable states
factor V leiden 15
embolic events
more common in older patients
e.g. infective endocarditis 11, marantic endocarditis
Other aetiological factors include 1,2:
splenic vascular disease
granulomatosis with polyangiitis 14
splenic arterial aneurysms 7
variant anatomy, e.g. wandering spleen, which may undergo splenic torsion
collagen vascular disease
pancreatitis 8
non-haematologic malignancies
blunt trauma: a segmental splenic infarct can occur as a rare complication 4
splenic artery compression, e.g. by pancreatic tumour
splenic embolisation
leukaemia (CML most common) 16
Radiographic features
The appearance of splenic infarction depends on the timing of imaging and the size of the infarct. Although once the infarct has become established, both ultrasound and CT are sensitive to the diagnosis, in the hyperacute setting CT with contrast is the modality of choice if the diagnosis is suspected 9.
Morphologically the typical infarct is of a pyramidal wedge of affected splenic tissue with the apex pointing towards the hilum, and the base on the splenic capsule.
As the infarct matures, the wedge of infarcted tissue can undergo one of three processes which will dictate imaging features:
resolution: no imaging findings
contraction/scarring
liquefaction
Ultrasound
Typically infarcts are hypoechoic compared to the rest of the spleen, although acutely they can be isoechoic and hard to identify. Sonographic features of acute splenic infarcts regarding shape can vary and include 5,9:
wedge-shaped (classic)
round
irregularly
smooth (uncommon)
During contrast-enhanced ultrasound, the infarcted area remains hypointense throughout all phases of the study 10.
As the infarct matures, if it undergoes contraction and scarring it will appear as a hyperechoic region with retraction of the capsule 9. If liquefaction occurs, the area may be rounded and anechoic (splenic pseudocyst).
CT
CT is often considered the imaging investigation of choice, ideally performed during the portal venous phase, to avoid confusing heterogeneous enhancement normally seen during arterial phase 2,7,9. Imaging features may vary with the stage of the infarct.
In the hyperacute phase, CT may show areas of mottled increased attenuation, representing areas of a haemorrhagic infarction.
There are various classical and non-classical patterns of established splenic infarcts on CT, which include 3,9:
peripheral, wedge-shaped hypoenhancing region: typical
multiple infarcts appear as hypodense non-enhancing lesions, with normal intervening enhancing splenic tissue.
global splenic infarction, entire spleen is hypoenhancing, e.g. in splenic torsion
infarction of a splenunculus 9
In the chronic phase, infarcts may disappear completely, but more commonly, they may reveal progressive volume loss caused by fibrotic contraction of the infarct, with hypertrophy of the surrounding normal spleen 7,9. Alternatively, if the infarct liquefies, a cystic lesion may be left with fluid density centrally 9.
Treatment and prognosis
Initial management usually consists of hydration, analgesics, and frequent monitoring, with the resolution of symptoms in 7-14 days. Splenectomy was performed for persistent symptoms or complications.
Complications
Some complications are encountered, more frequently in patients with an embolic aetiology. These include:
formation of a splenic pseudocyst(s)
infected splenic infarction leading to the formation of a splenic abscess
splenic haemorrhage
splenic rupture
Differential diagnosis
Often, when imaging appearances are typical, there is little differential diagnosis. When less typical, or when imaging is suboptimal, alternative diagnoses should be entertained, including 9:
normal inhomogeneous splenic enhancement (zebra or psychedelic spleen): seen during arterial phase CT
lymphoma
usually rounded rather than wedge-shaped
usually associated with splenomegaly and lymph node enlargement
lymphoma may cause secondary splenic infarction potentially muddying the waters
splenic abscess
either primary or superimposed infection on a liquefied infarct
splenic laceration
history of trauma
surrounding haematoma
note: splenic rupture can complicate infarction
5 types of haemoglobinopathies
Haemoglobinopathies
Dr Daniel J Bell◉ and Dr Pamela Mayhew et al.
A haemoglobinopathy is a genetic disorder which alters the structure of haemoglobin 1. The result is reduced oxygen-carrying capacity of the blood to the tissues, and other sequelae.
Clinical presentation
Clinical presentation varies, is related to hypoxia, and characteristically includes the following:
claudication
tachycardia
dyspnoea
vertigo
angina
Pathology
vascular occlusion leading to infarcts
necrosis
pathological fracture
osteomyelitis (100x more likely in sickle cell disease patients) 2
Classification
Types of haemoglobinopathies include the following, with the predominant type of abnormal haemoglobin in parentheses following the disorder.
sickle cell disease (HbS)
sickle cell trait (HbAS)
sickle cell-haemoglobin C (HbSC)
sickle cell-thalassaemia (HbS and HbA)
thalassaemia
alpha thalassaemia (deficient alpha-globin chain synthesis)
beta thalassaemia (deficient beta-globin chain synthesis)
thalassaemia major (homozygous) - Cooley anaemia
thalassaemia minor (heterozygous)
haemoglobin C disease (HbCC)
haemoglobin C trait (HbAC)
Radiographic features
The radiographic features of haemoglobinopathies vary and some are more specific for specific haemoglobinopathies (e.g. splenic sequestration in sickle cell). Generally, many common radiographic features are related to extramedullary haematopoiesis and infarctions as follows:
extramedullary haematopoiesis
Erlenmeyer flask deformity
hair-on-end appearance (characteristic, not pathognomonic, of thalassaemia)
rib expansion
calvarial alterations
diploic widening
outer table thinning
facial bone alterations
nasal and temporal bone expansion (obliteration of sinuses)
lateral displacement of orbits (hypertelorism)
dental displacement
infarctions
epiphyseal ischaemia (especially in the femoral head)
growth disturbances
osseous insufficiency
haemarthrosis
hand-foot syndrome (characteristic of sickle cell disease)

Sickle cell disease
Dr Mostafa El-Feky◉ and Dr Alexandra Stanislavsky◉ et al.
Sickle cell disease (SCD) (historically known as drepanocytosis) is a hereditary (autosomal recessive) condition resulting in the formation of abnormal haemoglobin (a haemoglobinopathy), which manifests as multisystem ischaemia and infarction, as well as haemolytic anaemia.
Haemoglobin SC (HbSC) disease, although a sickle cell disease subtype, with similarities to the classic condition, should ideally be considered as a distinct pathological entity 7.
Terminology
The term sickle cell disease is preferred to sickle cell anaemia for the name of the condition, not least because the former term reflects the fact that the condition has multisystem effects, rather than just a severe form of anaemia.
Epidemiology
There is no recognised gender predilection. The highest incidence occurs in individuals of African descent, followed by eastern Mediterranean and Middle Eastern populations. Malaria is the strongest known selective pressure on the human genome. The sickle cell mutation is prevalent in part as it confers a human genetic resistance to malaria as the abnormal haemoglobin has higher turnover and increased phagocytosis while sickled red cells have reduced cell-cell cytoadherence preventing the parasite from multiplying during the erythrocytic phase of its life cycle. It is estimated that approximately 8% of the African population is homozygous for sickle cell (where malaria is most prevalent).
Clinical presentation
The earliest manifestation is usually in early childhood, as babies are protected by elevated levels of fetal haemoglobin (HbF) in the first 6 months 3. The first presentation is commonly a painful vaso-occlusive crisis: sudden onset of bone or visceral pain due to microvascular occlusion and ischaemia, often in the setting of sepsis or dehydration. Sickle cell disease is known to have a wide spectrum of clinical presentations from completely asymptomatic to a severe overwhelming crisis.
Clinical findings are wide and include 1,6:
bone pain
bone infarction
subperiosteal haemorrhage
osteomyelitis
pulmonary
acute chest syndrome
recurrent pneumonia (impaired immunity due to functional asplenia)
chronic lung disease
abdominal
abdominal pain from vaso-occlusive crises
sequestration syndrome (rapid pooling of blood in the spleen leading to intravascular volume depletion)
haemolytic anaemia and extramedullary haematopoiesis
impaired immunity from autosplenectomy
multiple renal manifestations, with end result of renal failure 5
cerebral
stroke
cognitive impairment
ocular and orbital complications
central retinal artery occlusion (CRAO)
priapism
leg ulcers
Pathology
The disease results from a mutation in a gene coding for the beta chain of the haemoglobin molecule termed HbS. Specifically, there is a substitution of glutamine for valine at the 6th position in the beta-globin chain.
The term “sickle cell disease” applies to all patients who have two abnormal beta chains. The resultant haemoglobin molecules tend to clump together into long polymers, making the red blood cell (RBC) elongated (sickle-shaped), rigid and unable to deform appropriately when passing through small vessels, resulting in vascular occlusion. The abnormal RBCs are also removed from the bloodstream at an increased rate, leading to a haemolytic anaemia 1.
Individuals with one HbS beta chain and one normal beta chain are said to have the “sickle cell trait”. They are usually asymptomatic, although there is an association with an increased risk of renal medullary carcinoma 2. Perhaps of some consolation to individuals with the sickle cell trait is the increased resistance to malaria.
Individuals with one HbS beta chain and one haemoglobin C (HbC) beta chain, have a subtype of sickle cell disease known as haemoglobin SC (HbSC) disease 7.
Radiographic features
The radiographic manifestations of sickle cell disease are protean and are best discussed individually. Below is a summary of the main findings with links to individual articles.
Skeletal
Musculoskeletal manifestations of sickle cell disease are discussed separately. Three separate mechanisms can result in skeletal changes 6:
chronic anaemia resulting in expansion of the medullary spaces
vaso-occlusive crises resulting in bone infarcts and subperiosteal haemorrhages
infection
These, in turn, can predispose individuals to other complications, such as growth disturbance and pathological fractures.
Pulmonary
Pulmonary involvement is a leading cause of mortality among sickle cell disease patients and can be acute or chronic:
acute chest syndrome in sickle cell anaemia
chronic lung disease in sickle cell anaemia
Abdominal
Abdominal manifestations of sickle cell disease are discussed separately. Splenic infarction and subsequent functional asplenia tend to occur early in the disease. The hepatobiliary and renal systems are also commonly involved.
Cerebral
Cerebral manifestations of sickle cell disease are discussed separately. Stroke and cerebral atrophy are common neurologic sequelae of sickle cell disease.
Extramedullary haematopoiesis
Extramedullary haematopoiesis is discussed separately. Less common in sickle cell disease than in other haemolytic anaemias. The most common site is liver, followed by spleen, thorax, and adrenals 4.
Treatment and prognosis
Management of vaso-occlusive crises includes oxygen, hydration, and analgesia. Hydroxyurea decreases the severity of vaso-occlusive crises 1. Anaemia is usually well-tolerated, however, blood transfusions may be indicated in some cases. Bone marrow transplantation may provide a cure.
Sickle cell disease is associated with reduced life expectancy, whereas individuals with sickle cell trait have a normal life expectancy.
Spleen
imaging features on MRI, USS and CT
main malignancies 2
- byu the age of 15 the spleen reaches its normal adult size
- red pulp and white pulp which contirube to its tiger striped appearance during arterial phase
- red pul = filled with blood, up to one litre
- Usually 20HU less than liver and slightly more echogenic than liver (equal to left kidney).
- The splenic artery which usually arises from the coeliac trunk is essentially an end vessel with minimal collaters
- conclusion = infarct
- Pathology of the spleen
- congenital
- acquired
- mass
- As a general rule, most things in the spleen are benign with the exception of lymphoma or the very RARE primary Angiosarcoma
- MRI
- Bright on T2 (cf liver)
- dark on T1 (cf Liver)
- restricts on DWI
- its basically just a big watery lymphnode
Accessory spleens
- Crack the core p 218
- very common
- sulftur colloid could be used to differentiate a splenule from an enlarged pathologic lymphnode
- a patient post splenectomy for something like ITP or Autoimmune haemolytic anaemia, an accessory spleen could hypertrophy and present as a mass.
- Hypertrophy of an accessory spleen can also result in a recurrents of the original hemartoloicaly disease process.

- crack the core p218
- wandering spleen
- a normal spleen that waders off and is in an unexpected location
- bc of the laxity in the peritoneal ligaments holditing the spleen, a wandering spleen is a/w abnormalties of intestinal rotation.
- Unusual locations set the spleen up for tosion and subsequent infeaction
- chronic partial torsion can lead to slenomegally or gastric varicies.

- Splenosis
- Crack the core p218
- occurs post traumam whch a smashed spleen implants and then recruits blood supply
- usually multiple in the peritoneal cavity
- can occur any where
- Tc sulfur colloid can confirm that the implants are spleen and not ovarian mets

Gamna Gandy Bodies
- Siderotid nodule
- CTC p218
- These are small foci of hemorrhage in the splenic parenchyma that are usually a/w partial hypertension
- They are T2 dark
- Gradient is the most sensitive sequence
Marked splenomegaly with multiple splenic foci of low signal, they are tiny innumerable (Gamna Gandy bodies).
Case Discussion
Splenic siderotic nodules (also known as Gamna-Gandy bodies) of the spleen is most commonly encountered in portal hypertension. The pathophysiological process is the result of microhaemorhage resulting in haemosiderin and calcium deposition followed by fibroblastic reaction.

- Splenic Sarcoidosis CTC p219
- unknown eitiology
- NON-caseating granulomas which fomr in various tissues of the body
- Spleen involved in 50-80% of patients
- Splenomegally is usually the only sign
- however aggregates of granulomatous splenic tissue in some patients may appear on CT as numerous discrete 1-2cm hypodense nodules
- rarely it can cause a massive splenomegaly and possible rupture
- the GASTRIC antrum is the most common site in the GIT.
Splenic sarcoidosis
Dr Daniel J Bell◉ and Dr Subhan Iqbal◉ et al.
Splenic sarcoidosis is a non-caseating granulomatous involvement of the spleen, that presents with splenomegaly or multiple splenic nodules.
Clinical presentation
Clinical features of splenic sarcoidosis include 5,6:
pain
anaemia
abdominal pain and discomfort
splenic enlargement (is associated with involvement of the lungs and the liver) 9
Radiographic features
On imaging, splenic sarcoidosis mimics an infectious disease or neoplastic process 7,8.
CT
CT scan demonstrates homogeneous splenomegaly or the existence of numerous hypointense nodules, making it difficult to differentiate from metastases in the spleen 1-4,9.
MRI
T1: splenic lesions usually hypointense when related to the background parenchyma
T2: hypointense as compared to normal splenic parenchyma.
C+ (Gd): lesion shows no enhancement
Treatment and prognosis
Corticosteroids have a role in the treatment of sarcoidosis. Endoscopic ultrasound guided biopsy followed by splenectomy is the treatment of choice in cases of non-resolution 3.
Differential diagnosis
Differentials of splenic sarcoidosis include:
tuberculosis
lymphoma
metastasis
abscess
candidiasis (if the patient is immunosuppressive) 9
See also
sarcoidosis
sarcoidosis (abdominal manifestations)

- CTC p219
- Rare
- charactersied by multiple blood filled cyst-like spaes in a solid organ
- usually effects the liver
- whcen you see it in the spleen it is usually also in the liver.
- Unknown case
- for MCQs it occurs in
- women on OCP
- men on anabolic steroids
- AIDS
- rental Tx patients (up to 20%)
- Hodkins lymphoma
- usually asymptomatic
- but can explode spontaenously.
- Splenic peliosis
Dr Yuranga Weerakkody◉ et al.
Splenic peliosis is an unusual benign disorder characterised by the presence of irregular cystic blood-filled cavities.
Clinical presentation
Most patients are asymptomatic although very rarely patient can present with spontaneous organ rupture.
Associations
Recognised associations include
use of anabolic steroids
haematological conditions such as aplastic anaemia
wasting diseases such as
tuberculosis
AIDS
concurrent malignancy
Radiographic features
Ultrasound
May be seen as an echogenic mass lesion with numerous poorly defined foci of varying hypoechogenicity 5.
CT
On non-contrast-enhanced CT images, typically seen as a hypo-attenuating, multi-loculated lesion with well-defined septae within.
On contrast-enhanced CT images, the lesion may show significant enhancement with loss of definition of the lobules and septae. Fluid–fluid levels may also be present.
History and etymology
The term originates from the Greek pelios (Πήλιος), meaning dusky or purple, which arose from the macroscopic appearance of the lesion.
See also
peliosis
splenic peliosis
hepatic peliosis
splenic lesions and anomalies
https://www.ajronline.org/doi/pdfplus/10.2214/AJR.05.0167

- Splenic artery aneursym
- CTC p219
- most common visceral aterial aneurysm
- Pseudoaneurysm can occur in the setting of trauma and pancreatitis
- high incidence in women of child bearing age who have had two or more pregnancies
- 4 x more likely to get them
- 3 x more likely to rupture
- Usually sacular
- mid-to-distal artery
- Fix them when get to 2-3cm
- Colossal fuck up to avoid: don’t call them a hypervascular pancreatic islet cell mass and biopsy them


































































